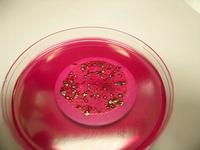
E Coli Bakterisi Özellikleri ve Faydaları Nelerdir?

Bakteri Hastalıkları Belirtileri ve Tedavisi
Bakteri hastalıkları, bakterilerin neden olduğu enfeksiyonlarla ortaya çıkan sağlık sorunlarıdır. Bu hastalıkların belirtileri, enfeksiyonun türüne göre değişiklik gösterir. Tedavi yöntemleri arasında antibiyotikler, semptomatik tedavi ve destekleyici yöntemler yer alır. Önlem almak, hastalık riskini azaltmada kritik öneme sahiptir.
Bakteri Hastalıkları: Belirtileri ve TedavisiBakteri hastalıkları, bakterilerin insan vücuduna girmesi ve çoğalması sonucunda ortaya çıkan enfeksiyonlardır. Bu hastalıkların belirtileri, etken bakterinin türüne ve vücuttaki etkileşime bağlı olarak değişiklik gösterebilir. Bakteriyel enfeksiyonlar, hafif semptomlardan ciddi sağlık sorunlarına kadar çeşitli sonuçlar doğurabilir. Bu makalede, bakteriyel hastalıkların belirtileri ve tedavi yöntemleri detaylı bir şekilde ele alınacaktır. Bakteri Hastalıklarının BelirtileriBakteriyel enfeksiyonların belirtileri genellikle enfeksiyonun bulunduğu bölgeye ve vücudun genel durumuna göre değişir. Aşağıda bazı yaygın belirtiler listelenmiştir:
Bu belirtilerin herhangi birinin varlığı, bir bakteriyel enfeksiyonun göstergesi olabilir ve derhal bir sağlık profesyoneli ile görüşülmelidir. Bakteri Hastalıklarının NedenleriBakteriyel hastalıklar, çeşitli yollarla vücuda giren bakterilerin neden olduğu enfeksiyonlardır. Bu nedenler arasında şunlar yer alır:
Bu faktörler, bakteriyel enfeksiyonların yayılmasına katkı sağlar ve kişisel hijyenin önemini vurgular. Bakteri Hastalıklarının TedavisiBakteriyel enfeksiyonların tedavisi, enfeksiyonun türüne ve ciddiyetine bağlı olarak değişir. Yaygın tedavi yöntemleri şunlardır:
Etkili bir tedavi planı için bir sağlık uzmanına danışmak her zaman en iyisidir. Önleme YöntemleriBakteriyel hastalıkların önlenmesi, bireylerin sağlıklarını korumak için önemlidir. Aşağıdaki önleme yöntemleri uygulanabilir:
Bu önlemler, bakteriyel enfeksiyonların riskini azaltmak için kritik öneme sahiptir. SonuçBakteri hastalıkları, dünya genelinde yaygın sağlık sorunları arasında yer almaktadır. Belirtilerinin tanınması ve zamanında tedavi edilmesi, enfeksiyonun yayılmasını önlemek açısından son derece önemlidir. Bakteriyel enfeksiyonların önlenmesi ve tedavi edilmesi için bireylerin sağlık bilgilerini artırmaları ve gerektiğinde profesyonel yardım almaları kritik bir rol oynamaktadır. Ek olarak, bakteriyel hastalıkların artan direnç sorunları nedeniyle, antibiyotiklerin dikkatli kullanımı ve araştırmaların devam etmesi gerekmektedir. Gelecek çalışmalarda, bakteriyel enfeksiyonların önlenmesi ve tedavisinde yeni yaklaşımların geliştirilmesi büyük önem taşımaktadır. |

Son zamanlarda 'helikopter bakterisi belirtileri' hakkında bir şeyler duydum. Bu bakterinin vücutta nasıl bir etki yarattığını ve belirtilerinin neler olduğunu öğrenmek istiyorum. Helikopter bakterisi belirtileri nelerdir? Bu konuda bilgi verebilir misiniz?
Helikopter Bakterisi Nedir?
Helikopter bakterisi, tıptaki adıyla Helicobacter pylori, mide ve on iki parmak bağırsağında yaşayan bir bakteri türüdür. Bu bakteri, birçok insanda bulunmasına rağmen bazı kişilerde mide rahatsızlıklarına yol açabilir.
Belirtileri
Helikopter bakterisi enfeksiyonu genellikle belirgin belirtiler göstermeyebilir, ancak bazı kişilerde aşağıdaki semptomlar görülebilir:
1. Mide Ağrısı: Sıklıkla karın bölgesinde hissedilen yanma veya keskin ağrılar.
2. Şişkinlik: Yemek yedikten sonra karın bölgesinde dolgunluk hissi.
3. Kusma: Mide bulantısı ve kusma durumu.
4. İştah Kaybı: Yemek yeme isteğinde azalma.
5. Sindirim Sorunları: Gaz, hazımsızlık ve gıda intoleransı gibi sorunlar.
6. Açık Mide Ülseri Belirtileri: Eğer bakteri mide ülserine yol açarsa, kanama, siyah dışkı veya kusmukta kan gibi daha ciddi belirtiler görülebilir.
Sonuç
Eğer bu belirtilerden birini veya birkaçını yaşıyorsanız, bir doktora danışmanız önemlidir. Helicobacter pylori enfeksiyonu tedavi edilebilir, bu nedenle erken teşhis ve uygun tedavi süreci oldukça önemlidir.
Boğmaca hastalığı hakkında daha fazla bilgi almak istiyorum. Ãocuklarımı bu hastalıktan nasıl koruyabilirim ve aşılar gerçekten etkili mi?
Boğmaca hastalığı, solunum yollarını etkileyen ve özellikle çocuklar için ciddi olabilen bir enfeksiyondur. Çocuklarınızı bu hastalıktan korumanın en etkili yolu aşılamadır. Boğmaca aşıları, çocukların bağışıklık sistemini güçlendirerek hastalığa karşı koruma sağlar. Ayrıca, ailedeki diğer bireylerin de aşılanmış olması önemlidir, çünkü hastalık kolayca bulaşabilir. Hijyen kurallarına dikkat etmek, elleri düzenli olarak yıkamak ve hastalığın belirtilerini erken fark ederek doktora başvurmak da koruyucu önlemler arasında yer alır. Aşılar, boğmaca hastalığına karşı oldukça etkilidir ve ciddi vakaların önlenmesinde büyük rol oynar.